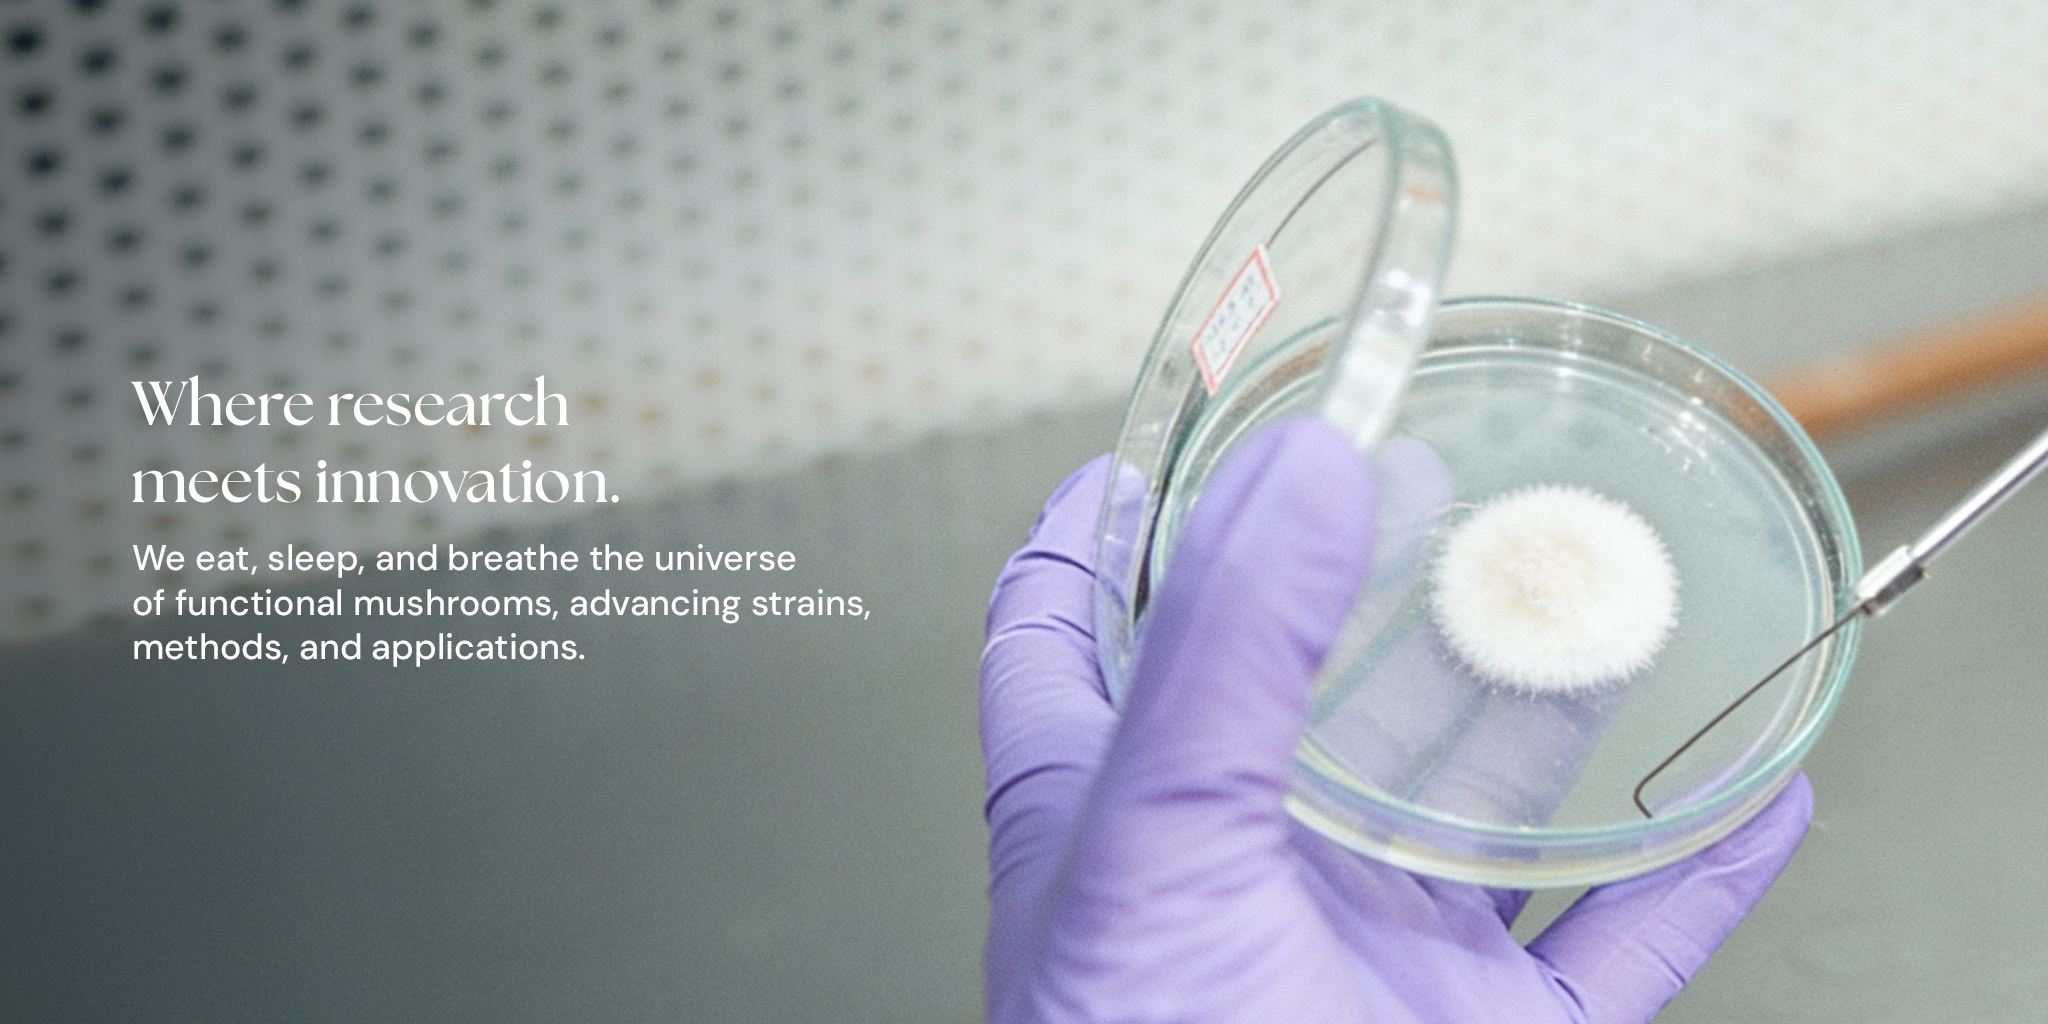

My first experience with both Lion’s Mane & Cordyceps has been very positive. I was feeling quite out of it on my first day of trying these out. Later that day, I felt energetic and clear headed!
I plan to keep these as part of my daily healthy routine! Also, absolutely love the packaging – feels like a premium product.
I’ve just finished my first bottle of Lion’s Mane extract. I totally felt a noticeable difference. My focus was better, I had less fog, overall I am now thinking with great depth and clarity. I’ve always believed in the value of functional health mushrooms. But, I was resigned to the belief that they would have an unpleasant bitter taste. Fungamental products have changed this belief for me. Their stuff is not just not unpleasant, it’s downright tasty. Highly recommend!
“As a professional MMA fighter, endurance is everything. Since I started using The Fungamental Co’s Cordyceps tincture, I’ve felt a real difference—it gives me more gas in my tank, round after round. My recovery time’s shorter, my energy stays steady, and I can push harder in training without burning out. This stuff’s become a part of my daily fight prep.”
“I’ll admit, I thought this whole mushroom craze was just a fad with the kids. But after trying The Fungamental Co’s Lion’s Mane tincture, I was surprised at how much it helped me focus. At 68, juggling my endless to-do lists suddenly feels easier. My mind’s clearer, my thoughts stay on track, and I finally feel like I’m keeping up with myself again.”